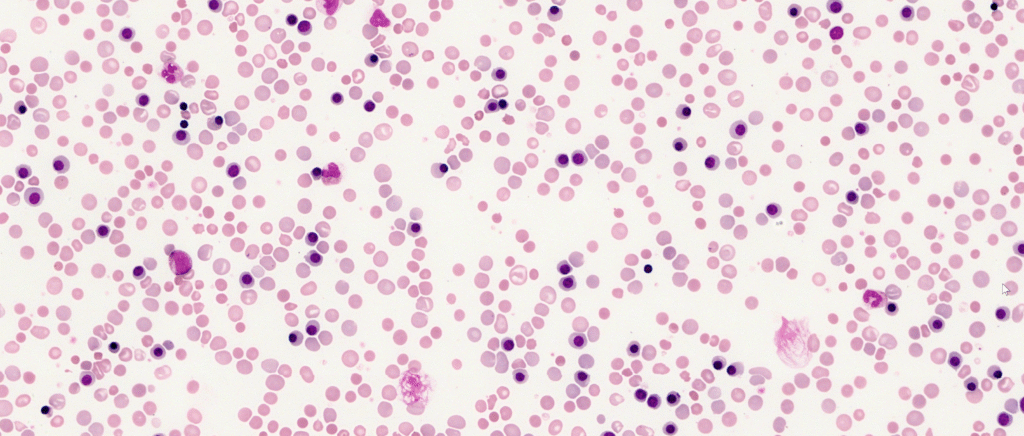
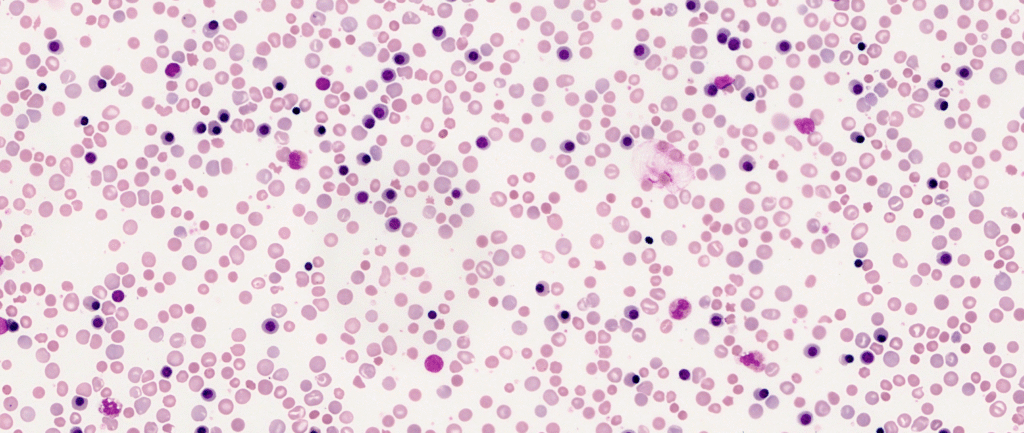
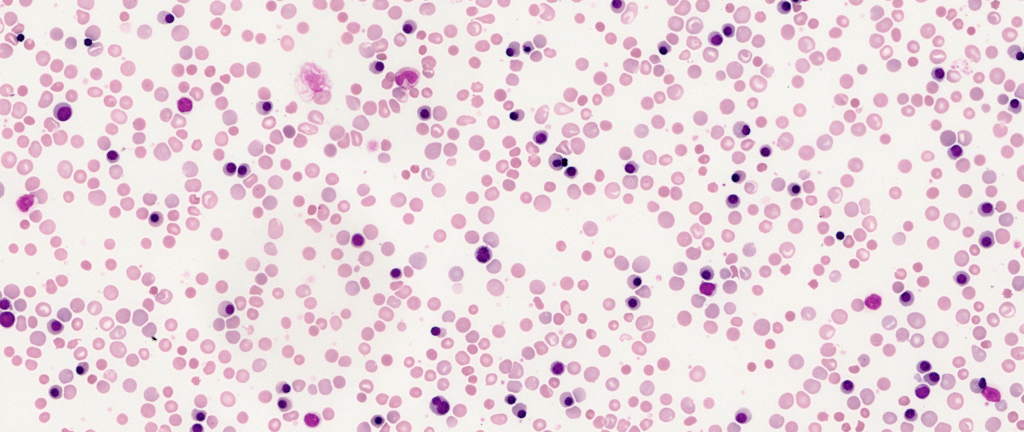

This week’s case comes from the Neonatal Intensive Care Unit. A newborn has presented with early-onset jaundice and a rapidly falling haemoglobin level. We’ve been asked to review the peripheral blood film to help narrow down the cause of the anaemia.

Looking at the morphology in the provided images, does the film show a “suppressed” marrow or an “active, stressed” marrow response? Look closely at the presence of immature forms.
The mother is RhD negative and, due to a series of missed appointments, refused/did not receive anti-D prophylaxis during her pregnancy.
What could be the diagnosis? Feel free to get involved on LinkedIn and Twitter (X), and I’ll reveal the diagnosis at the end of the week!
One Comment
The degree of nucleated red cells and spherocytes seen in this film would suggest a haemolytic disease of the new born due to Rh incompatibility. There are also target cells and few fragments